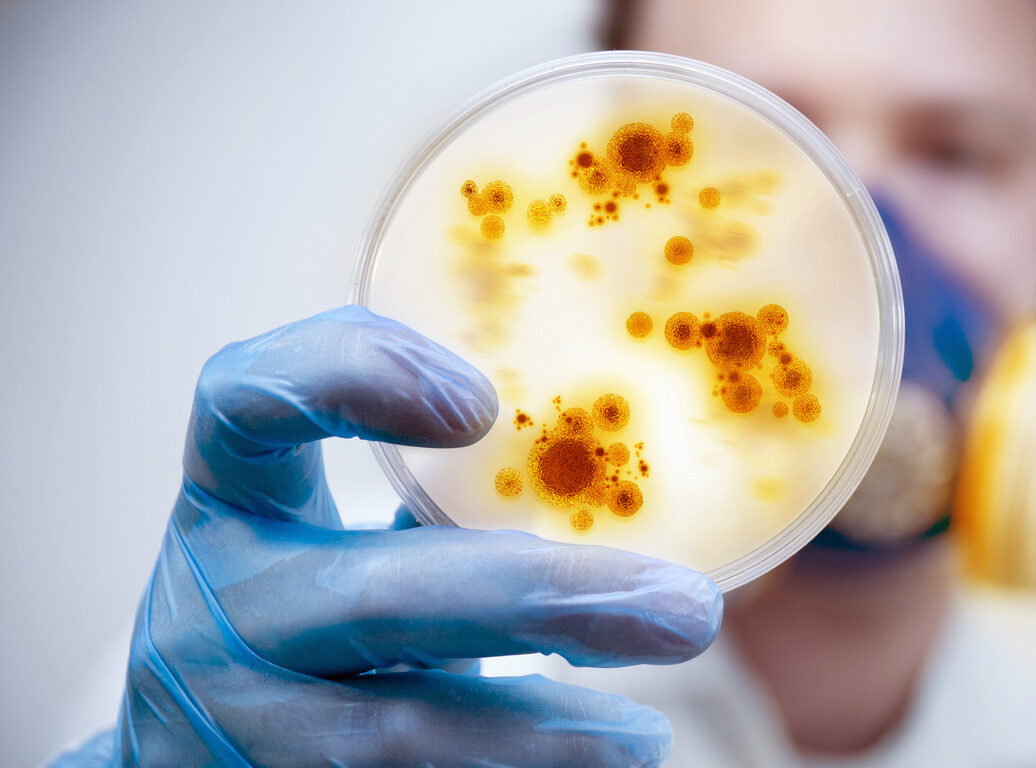

Invest in a Research Area
Research is important to the quality of health care in Canterbury.
“Modern medical advances have helped people live longer, healthier lives. We owe these improvements to decades of investment in medical research.”
– Ike Skelton
Most people think of medical research in terms of the discovery of penicillin or a cure for cancer. However, the indirect effects of research, while less obvious, are just as important to the quality of health care in Canterbury.
Over 62 years, the Foundation has funded more than $32 million in research into some of the world’s most devastating conditions such as: cancer, cystic fibrosis, heart disease, bowel disease, stroke, multiple sclerosis and Parkinson’s to name a few. In order to continue to provide a meaningful level of research funding, the Foundation is reliant on the goodwill and financial support of generous individuals, trusts and businesses from around our region and beyond.
We are able to fund medical research in the main areas below. Click on you research area of interest to make an investment.
How can you help?
While we have no current active research in the following, Alternative Health, Dental Health, Eye Health, Māori Health, Nutrition, Pasifika Health, and Sports Science, CMRF still supports these vital research areas. If you would like to invest in any of these areas you can contact us here or email invest@cmrf.org.nz.
SUPPORT OUR CANTERBURY BASED RESEARCH
Your donation directly supports the research projects we fund, helping to create a positive impact today and for the future.
BEQUESTS AND LIVING LEGACIES
Consider leaving a charitable gift in your Will to ensure that your legacy of generosity lives on, making a difference for years to come.
BECOME A MEMBER OF THE FOUNDATION
As a member, you’ll receive exclusive invitations to our AGM, community events, celebratory functions, and enjoy meeting our Board and Researchers.

Stay in touch with CMRF
Get all the latest news and insights to your inbox.